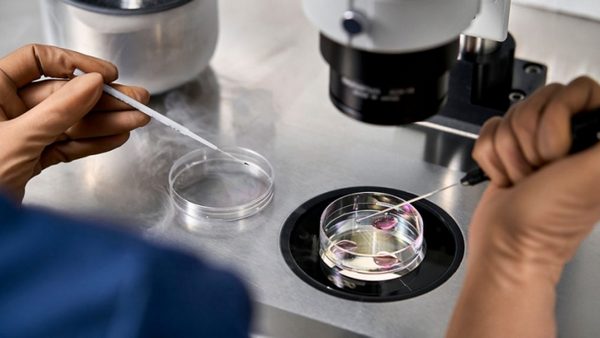

12 січня в Новозаводському районному суді міста Чернігів має відбутися засідання за справою №751/4095/21.1 справа ця обіцяє бути дуже гучною, адже відповідачем у ній виступає найстарша мати України — 76-річна чернігівка Валентина Підвербна. Предмет спору просто шокує — оспорювання материнства.
Справу №751 /4095/21_ було прийнято до розгляду ще 17 червня минулого року, із позовом до Валентини Підвербної до суду звернулася колишня харків’янка Оксана Спектор, яка зараз проживає за кордоном. Жінка підозрює, що для запліднення Валентини Григорівни використали її яйцеклітину, хоча дозволу на це вона не давала.
Нагадаємо: довгоочікувану донечку Анну-Марію Валентина Підвербна народила 23 лютого 2011 року. На той час їй було 65 років. До цього серед українок у такому віці не народжував щё ніхто, тож не дивно, що за свій «подвиг» Валентина Григорівна потрапила до Книги рекордів України, ставши найстаршою мамою країни. Ця історія облетіла сотні українських (і не тільки українських) ЗМІ. Люди дивилися відео-сюжети, читали статті, слухали радіоефіри, присвячені цій темі, і задавалися запитанням: що це — примха багатої жінки чи просто лікарський експеримент? Адже ні для кого не було секретом, що для запліднення Валентина Підвербна скористалася послугами донорів і завдячувати своїм материнським щастям вона має не природі, а Київському інституту генетики репродукції, створеному в 1999-му в рамках спільного проекту Українського центру медичної генетики та Чиказького інституту репродуктивної генетики. За офіційною інформацією, спеціалізується ця медична установа на діагностиці та лікуванні всіх видів безпліддя. Ефективність проведення штучного запліднення тут становить 65%, а випадки народження дітей жінками після 50 років далеко не поодинокі.
Народилася Анна-Марія здоровою, вагою 3 330 грамів і зростом 54 сантиметри. І ось уже 11-й рік живе з мамою (щасливо чи ні, це вже інше питання) в чернігівському мікрорайоні Масани. До минулого року в основному переймалися її долею працівники соцслужб, журналісти та небайдужі місцеві мешканці. То чому ж саме зараз на горизонті раптом з’явилася її «інша мама»?
— До 2021 року Оксана Борисівна навіть не задумувалась над тим, що Анна Підвербна може бути її дитиною. На це вказали певні обставини, — пояснює адвокат Оксани Спектор Сергій Вольфовський. — Річ у тому, що свого часу моя клієнтка лікувалася в тій же клініці, де робили екстракорпоральне запліднення Валентині Підвербній. її яйцеклітини залишилися в клініці на зберіганні. Історію Валентини Підвербної вона, як і всі інші українці, спостерігала з екрана телевізора і дуже раділа, що жінці навіть у такому віці допомогли завагітніти. Минув час, і Оксана Борисівна знову звернулася в цю клініку. Отоді й виявилося, що її яйцеклітини кудись зникли. Однак тоді з історією Валентини Підвербної вона це ніяк не пов’язала.
Усе стало очевидним лише минулого року. Оксана Спектор виїхала жити за кордон. Якось на роботі вона розговорилася з колегою про проблеми жінок, які не можуть народити дитину, і розповіла про «чудо-клініку» в Україні, де допомогли -завагітніти навіть 65-річній жінці. Разом вони почали шукати сюжети про цю історію в Ін-тернеті. Звісно, на очі потрапили не лише ті, що стосувалися безпосередньо народження дитини, а й більш свіжі. Отут Оксана Спектор уперше побачила вже 10-річну Ан-ну-Марію і… була шокована. Дівчинка виявилася дуже схожою на неї та її рідних. Плюс проблеми зі здоров’ям Анни-Марії, озвучені журналістами, збігалися з тими, що були в її родині.
— Зараз наша головна мета — призначення ДНК-експертизи, — каже Сергій Вольфовський. — Якщо материнство моєї клієнтки не підтвердиться, позов ми відкличемо, а Оксана Борисівна відшкодує витрати Валентини Підвербної на правничу допомогу. Якщо ж експертиза підтвердить, що Оксана Спектор — біологічна мати Анни Підвербної, моя клієнтка готова оспорювати материнство. Зі ЗМІ вона знає, що дівчинка живе не в дуже гарних умовах, а тому готова забрати її на виховання до себе, тож у цьому випадку подальша доля дитини буде вирішуватися вже в судовому порядку.
Отож припущення чернігівців, що на дитину претендує неблагополучна жінка, яка в майбутньому хоче загарбати квартиру Валентини Підвербної, не підтвердилися. І хто знає, можливо, саме зараз в Анни-Марії нарешті з’явився шанс на щасливе безтурботне дитинство?
«Гарт» №1 (3066) вsд 6 січня 2022, Катерина Дроздова
Хочете отримувати головне в месенджер? Підписуйтеся на наш Telegram.








